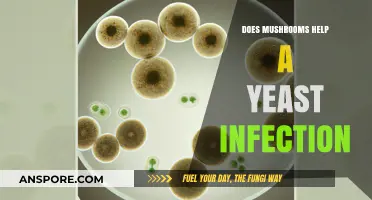
Mushrooms: Natural Remedy for Yeast Infections?

Psilocybin, the psychoactive compound in magic mushrooms, has been the subject of recent research into its potential to help terminally ill patients overcome their fear of death. In a study of 3,000 adults, Johns Hopkins Medicine researchers found that both psychedelic experiences and non-drug-related near-death experiences reduced anxiety about death and had a lasting positive effect. Two other studies found that cancer patients felt less depressed after taking psilocybin, suggesting that psychedelic therapy can help patients face their mortality and live more fully. While results vary and there are potential risks, psilocybin has been shown to be effective in reducing fear and improving the quality of life for those facing life-threatening illnesses.
| Characteristics | Values |
|---|---|
| Number of participants in the survey | 3,000 |
| Participants' groups | Those who had a near-death experience, those who had used psychedelics |
| Percentage of people less afraid of death | 90% |
| Results | Less fear of death and dying, positive effects, personal meaning, spiritual significance, psychological insight |
| Risks | Fear and discomfort |
| States that have legalized the therapeutic use of psychedelic mushrooms | Oregon, Colorado |
Explore related products
What You'll Learn
- Psilocybin, the active component of magic mushrooms, reduces fear of death
- Psychedelic therapy helps terminal patients overcome fear of death
- Psychedelics can be an effective complement to psychological support for end-of-life patients
- A single dose of psilocybin diminishes depression and anxiety in patients with advanced cancer
- The therapeutic use of psychedelic mushrooms has been legalized in Oregon and decriminalized in Colorado

Psilocybin, the active component of magic mushrooms, reduces fear of death
Psilocybin, the psychoactive compound in magic mushrooms, has been found to significantly reduce fear and anxiety in patients with advanced cancer. In a recent study, researchers at Johns Hopkins University and New York University investigated the effects of a single dose of psilocybin on patients with advanced cancer. The results showed that psilocybin substantially diminished depression and anxiety, providing a sense of deeper meaning and understanding that reduced the fear of death.
This builds on previous research, such as a 2016 randomized clinical trial that found psilocybin lessened depression and anxiety among 51 patients with life-threatening cancer. Additionally, a survey study of more than 3,000 adults compared the effects of psychedelic experiences with non-drug-related near-death experiences. The study found that participants in both groups reported having less fear of death and a more positive outlook, with a better understanding of personal meaning and spiritual significance.
The potential of psilocybin in treating fear of death is also supported by individual accounts, such as that of Dinah Bazer, a 69-year-old ovarian cancer survivor. She reported that her anxiety and fear of cancer returning were consuming her life, but after undergoing treatment with psilocybin, she found relief from her fears. Similarly, Rodrigo Niño, a former cancer patient, experienced a reduction in his fear of dying after undergoing treatment with psychedelic drugs, specifically ayahuasca.
While psilocybin shows promise in reducing the fear of death, it is important to acknowledge that there are potential risks and challenges associated with its use. Some individuals may experience fear or discomfort during their psychedelic journey, and proper screening and preparation procedures are necessary to mitigate these risks. However, these challenging experiences can also be cathartic and lead to personal growth and transcendence.
In conclusion, psilocybin, the active component of magic mushrooms, has been found to reduce fear of death in patients with advanced cancer. Through its ability to diminish depression and anxiety, psilocybin provides individuals with a sense of peace and understanding, allowing them to face their mortality with reduced fear and a more positive outlook on life and death. Further research is needed to fully understand the potential therapeutic benefits of psilocybin in ameliorating the fear of death and to develop clinical applications.
Mushroom Spores: Nature's Intricate Dispersal Methods
You may want to see also

Psychedelic therapy helps terminal patients overcome fear of death
Psychedelic therapy has emerged as a promising treatment for terminal patients struggling with a fear of death. This alternative approach involves the use of psychedelic substances, such as psilocybin, the active compound in "magic" mushrooms, to alleviate anxiety and depression associated with end-of-life concerns.
Research in this field has revealed encouraging findings. In a study by Johns Hopkins Medicine, over 3,000 adults who had psychedelic experiences or near-death experiences reported reduced fear of death and a lasting positive impact on their attitudes. Similarly, two long-awaited studies published in the Journal of Psychopharmacology combined psychedelic therapy with psychotherapy for cancer patients, resulting in decreased depression and anxiety.
The potential benefits of psychedelic therapy extend beyond cancer patients. A separate study by the Beckley Foundation and Imperial Research Programme found that psilocybin could help individuals with treatment-resistant depression. Furthermore, it addresses the psychological distress that approximately 40% of cancer patients experience due to their illness.
While psychedelic therapy offers hope, it is not without risks. About 30% of participants in some studies reported fear or discomfort during their psychedelic experiences. However, these challenging moments can also be cathartic, leading to personal meaning and transcendence.
As research progresses, there is a growing recognition of the potential for psychedelic therapy to transform how we approach end-of-life care, providing comfort and peace to those facing mortality.
Drying Psychedelic Mushrooms: A Step-by-Step Guide
You may want to see also

Psychedelics can be an effective complement to psychological support for end-of-life patients
Psychedelics, such as psilocybin, the active compound in magic mushrooms, have been the subject of recent research exploring their potential to alleviate end-of-life anxiety and fear of death. A growing body of evidence suggests that when combined with psychotherapy, psychedelics can effectively complement psychological support for end-of-life patients.
In a notable study by Johns Hopkins University and New York University, cancer patients who received a single dose of psilocybin experienced substantial reductions in depression and anxiety. This research adds to a growing body of knowledge about the therapeutic potential of psychedelics, which were first explored in the 1960s.
One of the key advantages of using psychedelics in end-of-life care is their ability to provide a sense of deeper meaning and understanding. As one researcher explained, the psilocybin experience enables individuals to grasp that "in the largest frame, everything is fine and that there is nothing to be fearful of." This sense of buoyancy and clarity can be transformative for individuals facing their mortality.
However, it is important to acknowledge that the use of psychedelics is not without risks. About 30% of participants in one study reported some fear or discomfort during their experience. Proper screening, preparation, and guidance are crucial to mitigating these risks and ensuring a safe and therapeutic experience.
While more research is needed to fully understand the potential of psychedelics in end-of-life care, initial findings suggest that they can play a valuable role in helping individuals face their mortality with reduced fear and increased psychological well-being. By combining psychedelics with psychological support, we may be able to provide a more comprehensive and effective approach to end-of-life care.
Mushrooms on Toast: Healthy or Not?
You may want to see also
Explore related products

A single dose of psilocybin diminishes depression and anxiety in patients with advanced cancer
In a clinical trial, researchers at NYU Langone Medical Center found that a single dose of psilocybin, a hallucinogenic compound in psychedelic mushrooms, significantly reduced mental anguish in distressed cancer patients for months. The study, published in the Journal of Psychopharmacology, showed that one-time treatment with psilocybin brought relief from distress that lasted for more than six months in 80% of the monitored subjects, based on clinical evaluation scores for anxiety and depression.
Psilocybin has been studied for decades and is known to activate parts of the brain impacted by serotonin, a chemical that controls mood and anxiety. Imbalances in serotonin have been linked to depression. In the NYU Langone study, patients reported improvements in their quality of life, including going out more, having greater energy, getting along better with family members, and doing well at work. Several also reported increased feelings of spirituality, unusual peacefulness, and altruism.
Similar results were found in a study conducted at Johns Hopkins University, which was published in the Journal of Psychopharmacology alongside the NYU Langone study. This study found that a single treatment with psilocybin produced sustained decreases in anxiety and depression among patients with a life-threatening cancer diagnosis. In a larger, randomized, double-blind trial, high doses of psilocybin produced large decreases in clinician- and self-rated measures of depressed mood and anxiety, along with increases in quality of life, life meaning, and optimism.
Psilocybin-assisted therapy has also been found to be safe and feasible for patients with cancer and depression. A phase 2 trial investigated the effects of a single dose of psilocybin administered in a group therapy setting with individual therapist-to-patient psychological support. The results suggested efficacy, with clinically meaningful reductions in depressive symptoms.
While psilocybin has shown promising results in treating depression and anxiety in cancer patients, it is important to note that it should not be consumed without supervision by a physician and a trained counselor. Additionally, future studies are needed to further understand the potential clinical use of psilocybin in ameliorating suffering related to the fear of death.
Agaricus Mushroom Extract: Nature's Superfood
You may want to see also

The therapeutic use of psychedelic mushrooms has been legalized in Oregon and decriminalized in Colorado
Psilocybin, the active ingredient in "magic" mushrooms, has been found to have therapeutic benefits for people with a range of conditions, including severe mental health problems, alcohol addiction, and depression. In a survey study of more than 3000 adults, Johns Hopkins Medicine researchers compared psychedelic experiences with near-death experiences and found notable similarities in people’s attitudes toward death. Participants in both groups reported having less fear of death and dying after the experience, as well as a lasting positive effect, providing personal meaning, spiritual significance, and psychological insight.
In light of these findings, Oregon became the first state to legalize the therapeutic use of psychedelic mushrooms in 2020. The measure allows regulated use of psychedelic mushrooms in a therapeutic setting, creating a two-year period to work out regulatory details, including the qualifications required of therapists overseeing its use. Oregon residents over the age of 21 who pass a screening can access these services for "personal development". The state will not allow the retail sale of psilocybin; instead, it will be administered at licensed facilities with trained facilitators present.
Following Oregon's lead, Colorado voters approved Proposition 122 in 2022, which decriminalized the use of psychedelic mushrooms. This initiative removes criminal penalties for possessing and using certain psychedelics for personal use, including psilocybin, psilocin, dimethyltryptamine (DMT), ibogaine, and mescaline. While it is still illegal to sell these substances, individuals can grow and share them (except for ibogaine). Colorado can now issue licenses to psychedelic mushroom therapy facilitators, who will conduct therapeutic sessions in a secure, regulated environment. This shift underscores the state's commitment to exploring alternative solutions to pressing mental health concerns.
While the therapeutic use of psychedelic mushrooms has been legalized in Oregon and decriminalized in Colorado, it is important to note that these substances are still illegal at the federal level. As such, there are ongoing debates about the regulatory framework for the production and sale of these compounds, as well as the potential risks and challenges associated with their use. Nonetheless, the growing recognition of the therapeutic benefits of psilocybin has sparked a national conversation about alternative approaches to mental health treatment and end-of-life care.
Mellow Mushroom: Baton Rouge Delivery Options Explored
You may want to see also
Frequently asked questions
Psychedelics are potent psychoactive substances that alter cognition, changing the user’s mood and perceptions by acting on neural circuits in the brain.
Psychedelics have been shown to complement psychological support for end-of-life patients. They help patients overcome the fear of death, freeing them to live more fully.
Psilocybin, the psychoactive compound in "magic" mushrooms, is one example of a psychedelic that has been shown to help with the fear of dying. Other examples include LSD, ayahuasca, and DMT.
Yes, there are potential risks associated with psychedelics. About 30% of people in one study reported some fear or discomfort during the experience. However, these experiences can often be short-lived and cathartic, serving as doorways into personal meaning and transcendence.
The availability of psychedelic therapy varies by location. In the United States, the Right to Try laws in 41 states give gravely ill patients access to experimental drugs. In 2020, Oregon became the first state to legalize the therapeutic use of psychedelic mushrooms, and Colorado recently decriminalized magic mushrooms.